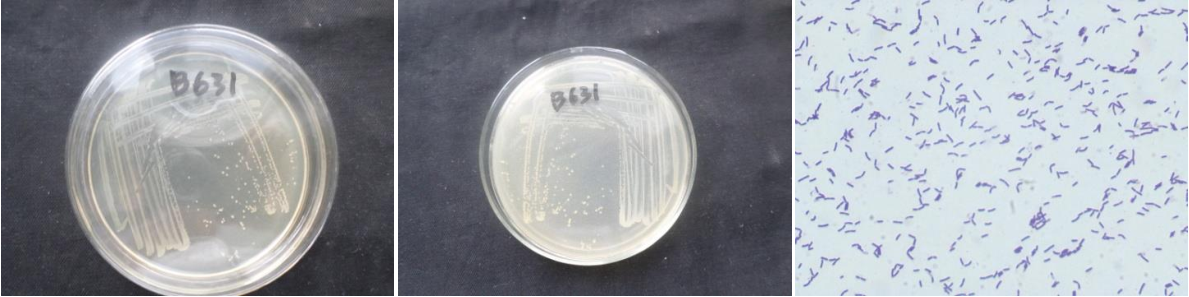

Loading...
| StrainNO | B631 |
| Classification | Bacillus |
| 16s rDNA sequence | GCTATACATGCAAGTCGAGCGGACAGAAGGGAGCTTGCTCCCGGATGTTAGCGGCGGACGGGTGAGTAACACGTGGGTAACCTG CCTGTAAGACTGGGATAACTCCGGGAAACCGGAGCTAATACCGGATAGTTCCTTGAACCGCATGGTTCAAGGATGAAAGACGGT TTCGGCTGTCACTTACAGATGGACCCGCGGCGCATTAGCTAGTTGGTGGGGTAATGGCTCACCAAGGCGACGATGCGTAGCCGA CCTGAGAGGGTGATCGGCCACACTGGGACTGAGACACGGCCCAGACTCCTACGGGAGGCAGCAGTAGGGAATCTTCCGCAATGG ACGAAAGTCTGACGGAGCAACGCCGCGTGAGTGATGAAGGTTTTCGGATCGTAAAGCTCTGTTGTTAGGGAAGAACAAGTGCGA GAGTAACTGCTCGCACCTTGACGGTACCTAACCAGAAAGCCACGGCTAACTACGTGCCAGCAGCCGCGGTAATACGTAGGTGGC AAGCGTTGTCCGGAATTATTGGGCGTAAAGGGCTCGCAGGCGGTTTCTTAAGTCTGATGTGAAAGCCCCCGGCTCAACCGGGGA GGGTCATTGGAAACTGGGAAACTTGAGTGCAGAAGAGGAGAGTGGAATTCCACGTGTAGCGGTGAAATGCGTAGAGATGTGGAG GAACACCAGTGGCGAAGGCGACTCTCTGGTCTGTAACTGACGCTGAGGAGCGAAAGCGTGGGGAGCGAACAGGATTAGATACCC TGGTAGTCCACGCCGTAAACGATGAGTGCTAAGTGTTAGGGGGTTTCCGCCCCTTAGTGCTGCAGCTAACGCATTAAGCACTCC GCCTGGGGAGTACGGTCGCAAGACTGAAACTCAAAGGAATTGACGGGGGCCCGCACAAGCGGTGGAGCATGTGGTTTAATTCGA AGCAACGCGAAGAACCTTACCAGGTCTTGACATCCTCTGACAACCCTAGAGATAGGGCTTTCCCTTCGGGGACAGAGTGACAGGTGGTGCATGGTTGTCGTCAGCTCGTGTCGTGAGATGTTGGGTTAAGTCCCGCAACGAGCGCAACCCTTGATCTTAGTTGCCAGC ATTTAGTTGGGCACTCTAAGGTGACTGCCGGTGACAAACCGGAGGAAGGTGGGGATGACGTCAAATCATCATGCCCCTTATGAC CTGGGCTACACACGTGCTACAATGGACAGAACAAAGGGCTGCGAGACCGCAAGGTTTAGCCAATCCCATAAATCTGTTCTCAGT TCGGATCGCAGTCTGCAACTCGACTGCGTGAAGCTGGAATCGCTAGTAATCGCGGATCAGCATGCCGCGGTGAATACGTTCCCG GGCCTTGTACACACCGCCCGTCACACCACGAGAGTTTGCAACACCCGAAGTCGGTGAGGTAACCTTTATGGAGCCAGCCGCCGA AGGTGGGGCAGATGATTGGGGTGAAGTCGTAACAAGAGC |
| Strain Morphology Photos | |
| Morphological Description | round;soybean milk yellow;edge neatly;steamed bun shaped;slippy;sticky;waxy;Rod;having spore;bias in budding spores |